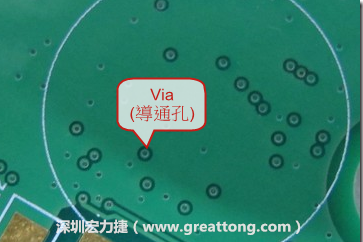

如果你有機(jī)會(huì)拿起一片
電路板,稍微觀察一下會(huì)發(fā)現(xiàn)這電路板上有著許多大大小小的孔洞,把它拿起來對(duì)著天花板上的電燈看,還會(huì)發(fā)現(xiàn)許多密密麻麻的小孔,這些孔洞可不是放在哪里擺好看的,每個(gè)孔洞都是有其目的而被設(shè)計(jì)出來的。
這些孔洞大體上可以分成
PTH(Plating Through Hole,
電鍍通孔)及
NPTH(Non Plating Through Hole,
非電鍍通孔)兩種,這里說「通孔」是因?yàn)檫@種孔真的就是從電路板的一面貫穿到另外一面,其實(shí)電路板內(nèi)除了通孔外,還有其他不是貫穿電路板的孔,有興趣的可以先參考這篇文章:
PCB名詞解釋:通孔、盲孔、埋孔。
那要如何區(qū)分PTH與NPTH這兩種通孔呢?
其實(shí)很簡(jiǎn)單,參考文章最前面的圖片,只要看看孔壁有沒有亮亮的電鍍痕跡就可以判斷了,有電鍍痕跡的孔就是PTH,沒有電鍍痕跡的孔就是NPTH。
那NPTH(非電鍍通孔)有何用途?
如果你稍微留點(diǎn)心,會(huì)發(fā)現(xiàn)NPTH的孔徑通常會(huì)比PTH來得大,因?yàn)镹PTH絕大部分是用來作為鎖螺絲用的,有的則是用于安裝一些連結(jié)外面的連接器固定用。
另外,有些也會(huì)在板邊(break-away,折斷邊)設(shè)計(jì)NPTH來作為測(cè)試治具的定位之用,早期的時(shí)候也會(huì)拿來當(dāng)作SMT打件/貼件時(shí)固定電路板之用,現(xiàn)在SMT的打件機(jī)器大多使用夾持的方式而不用頂針來固定電路板了。
那PTH(電鍍通孔)有何用途?Via(導(dǎo)通孔)又是什么?
一般在電路板的PTH孔有兩種用途,一種是用來焊接傳統(tǒng)DIP零件腳用的,這些孔的孔徑必須比零件的焊接腳直徑來得大一些,這樣才能把零件插到孔中。
另一種比較小的PTH,通常稱其為via(導(dǎo)通孔),是用來連接及導(dǎo)通電路板(PCB)的兩層或多層之間的銅箔線路用的,因?yàn)镻CB是由許多的銅箔層堆迭累積而成,每一層銅箔(copper)之間都會(huì)再鋪了一層絕緣層,也就是說銅箔層彼此之間不能互通,其訊號(hào)的連接就是靠via,所以中文才會(huì)稱其為「導(dǎo)通孔」。
如上圖是電路板的側(cè)面剖面圖,把它想成是玻璃瓶?jī)?nèi)的螞蟻巢穴,這是一片有六層銅箔的PCB,我們可以把這片PCB想像成有好像六層樓的大廈,每一層銅箔就代表著一層樓,而via(導(dǎo)通孔)就相當(dāng)于連接樓層的樓梯,而且這棟大廈的樓梯可以有好幾座,不過這樓梯可不一定每一座都會(huì)連接到所有的樓層就是了,它可能只有連接第三層與第四層樓,其他都不通,這樣子的孔(via)我們稱之為【Buried Via Hole(埋孔)】,因?yàn)閺耐饷嫱耆床坏接锌椎拇嬖凇R驗(yàn)関ia的目的在導(dǎo)通不同層的銅箔,需要電鍍才能導(dǎo)通,所以via也是PTH的一種。
不過現(xiàn)在的via大多會(huì)用綠漆(solder mask)覆蓋起來,就像上圖的樣子,尤其是手機(jī)板,因?yàn)榘遄由系牧慵椒旁矫芗行¬ia甚至?xí)环旁诹慵恼路剑瑸榱朔乐沽慵cvia不小心短路而產(chǎn)生品質(zhì)問題,所以大多會(huì)用綠漆覆蓋via。因?yàn)橛行﹙ia上面會(huì)有印刷錫膏,板子流經(jīng)回焊爐(reflow)時(shí),錫膏是很有可能從via流過去到板子的另一面而造成短路問題,所以現(xiàn)在的PCB工藝大多會(huì)把via的孔徑做得小小,然后用綠漆覆蓋以避免將來可能造成的品質(zhì)問題。
當(dāng)然使用綠漆覆蓋于導(dǎo)通孔的工法有許多人覺得會(huì)有品質(zhì)風(fēng)險(xiǎn),因?yàn)榭赡軙?huì)有蓋孔不全或是化學(xué)藥劑殘留而導(dǎo)致腐蝕的風(fēng)險(xiǎn),但不可否認(rèn)的使用綠漆蓋孔還是目前最便宜且可以接受的填孔方式。除了使用綠漆蓋孔外,也有人使用樹脂先填孔再用綠漆蓋孔,這樣的工法比較符合品質(zhì)的要求,但多了一道工序,費(fèi)用當(dāng)然得往上加。另外,如果是焊盤/焊墊上的通孔或盲孔,一般我們會(huì)要求使用銅塞孔,最后在做表面處理,以避免錫膏流進(jìn)去通孔的風(fēng)險(xiǎn)。
深圳宏力捷推薦服務(wù):PCB設(shè)計(jì)打樣 | PCB抄板打樣 | PCB打樣&批量生產(chǎn) | PCBA代工代料